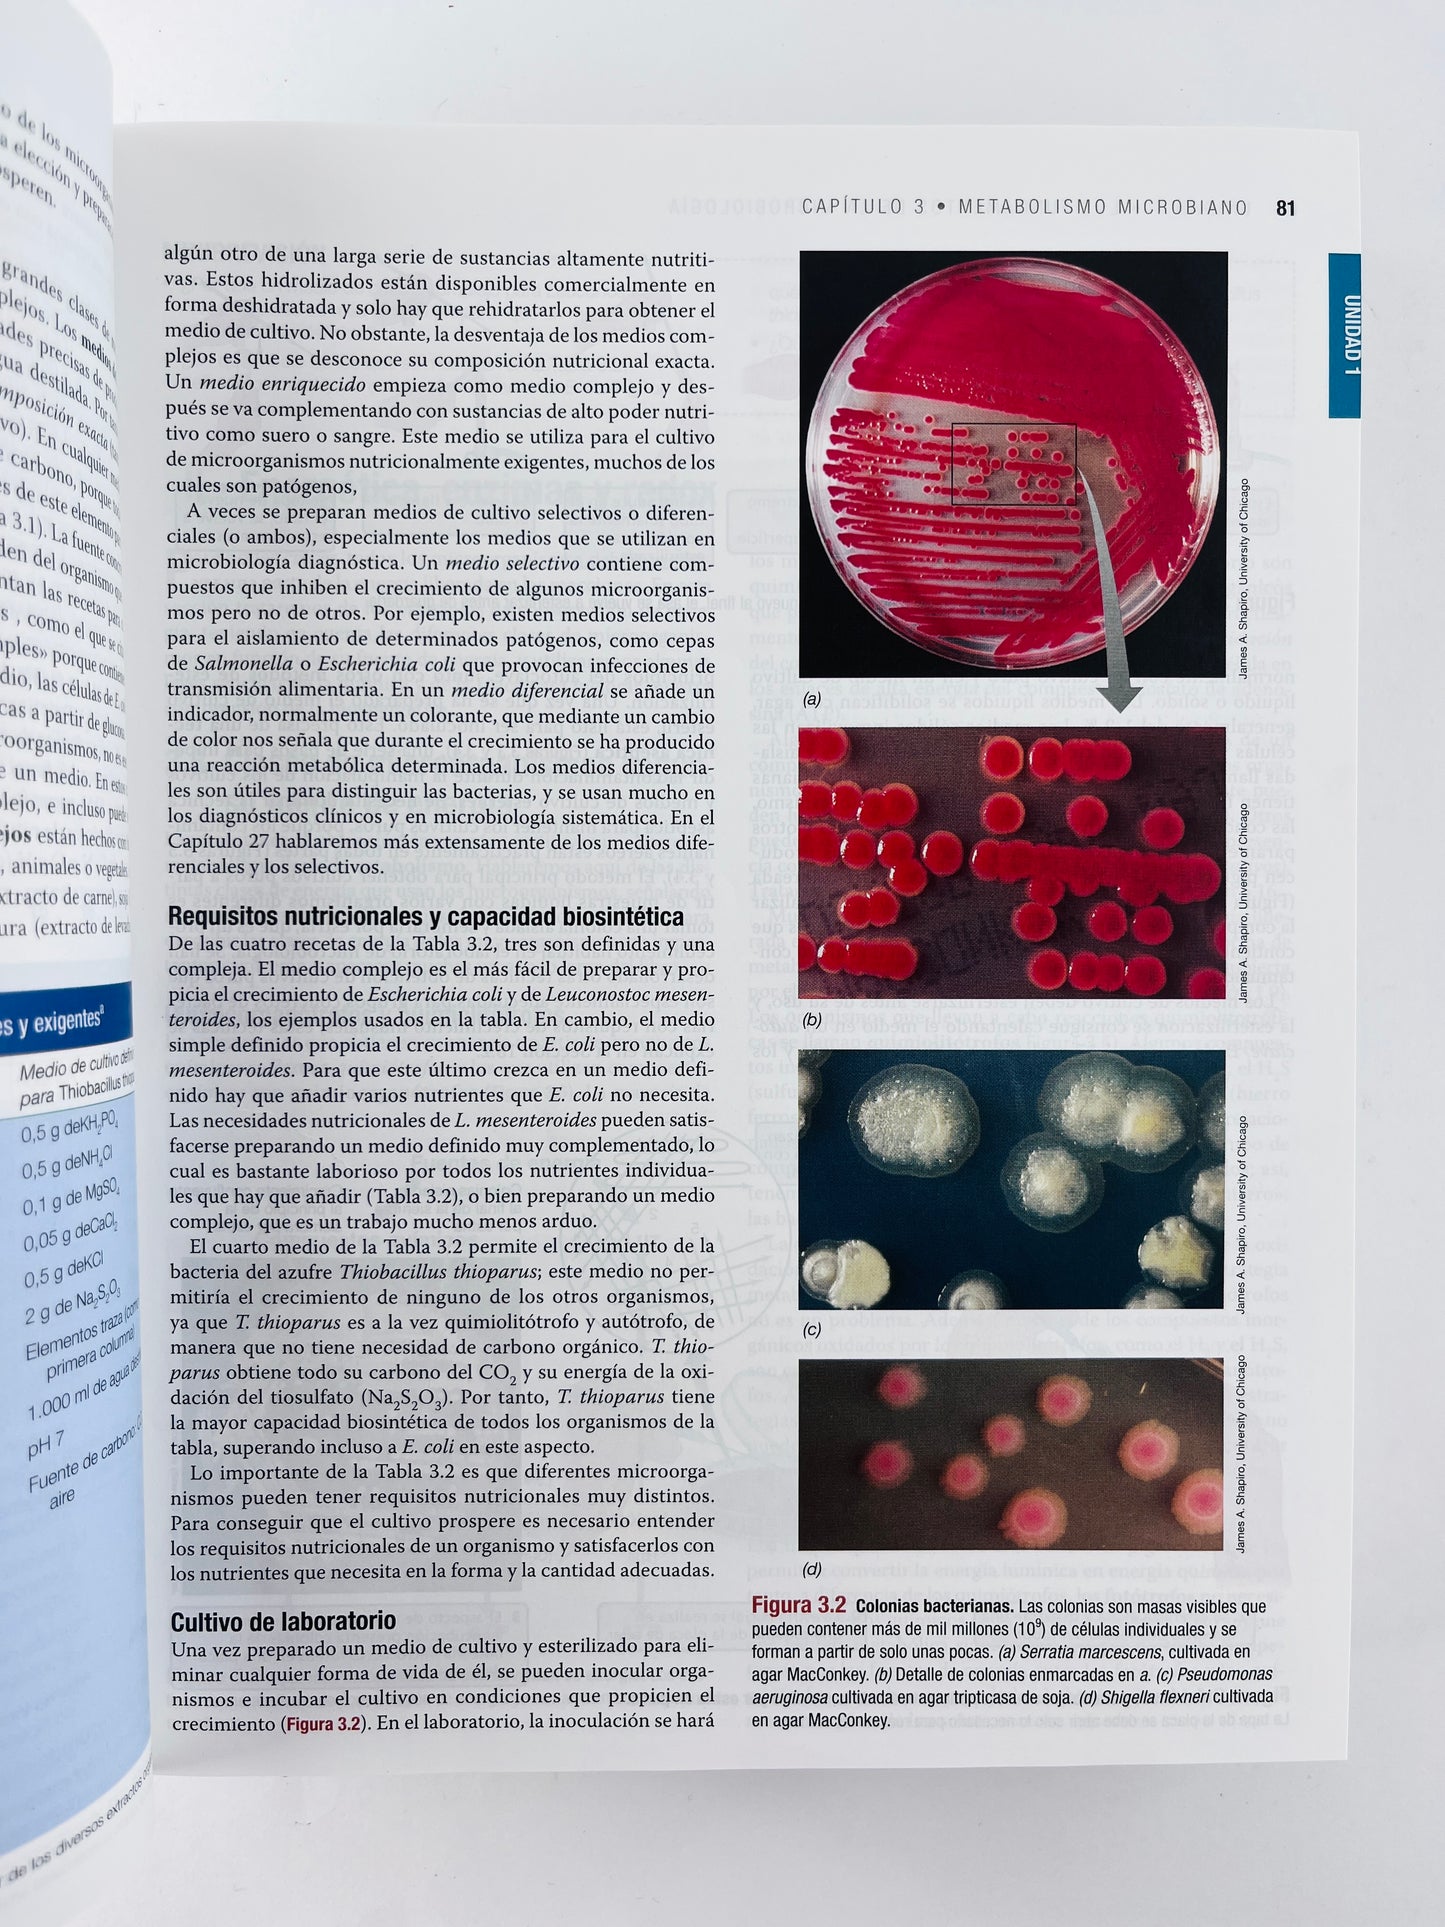
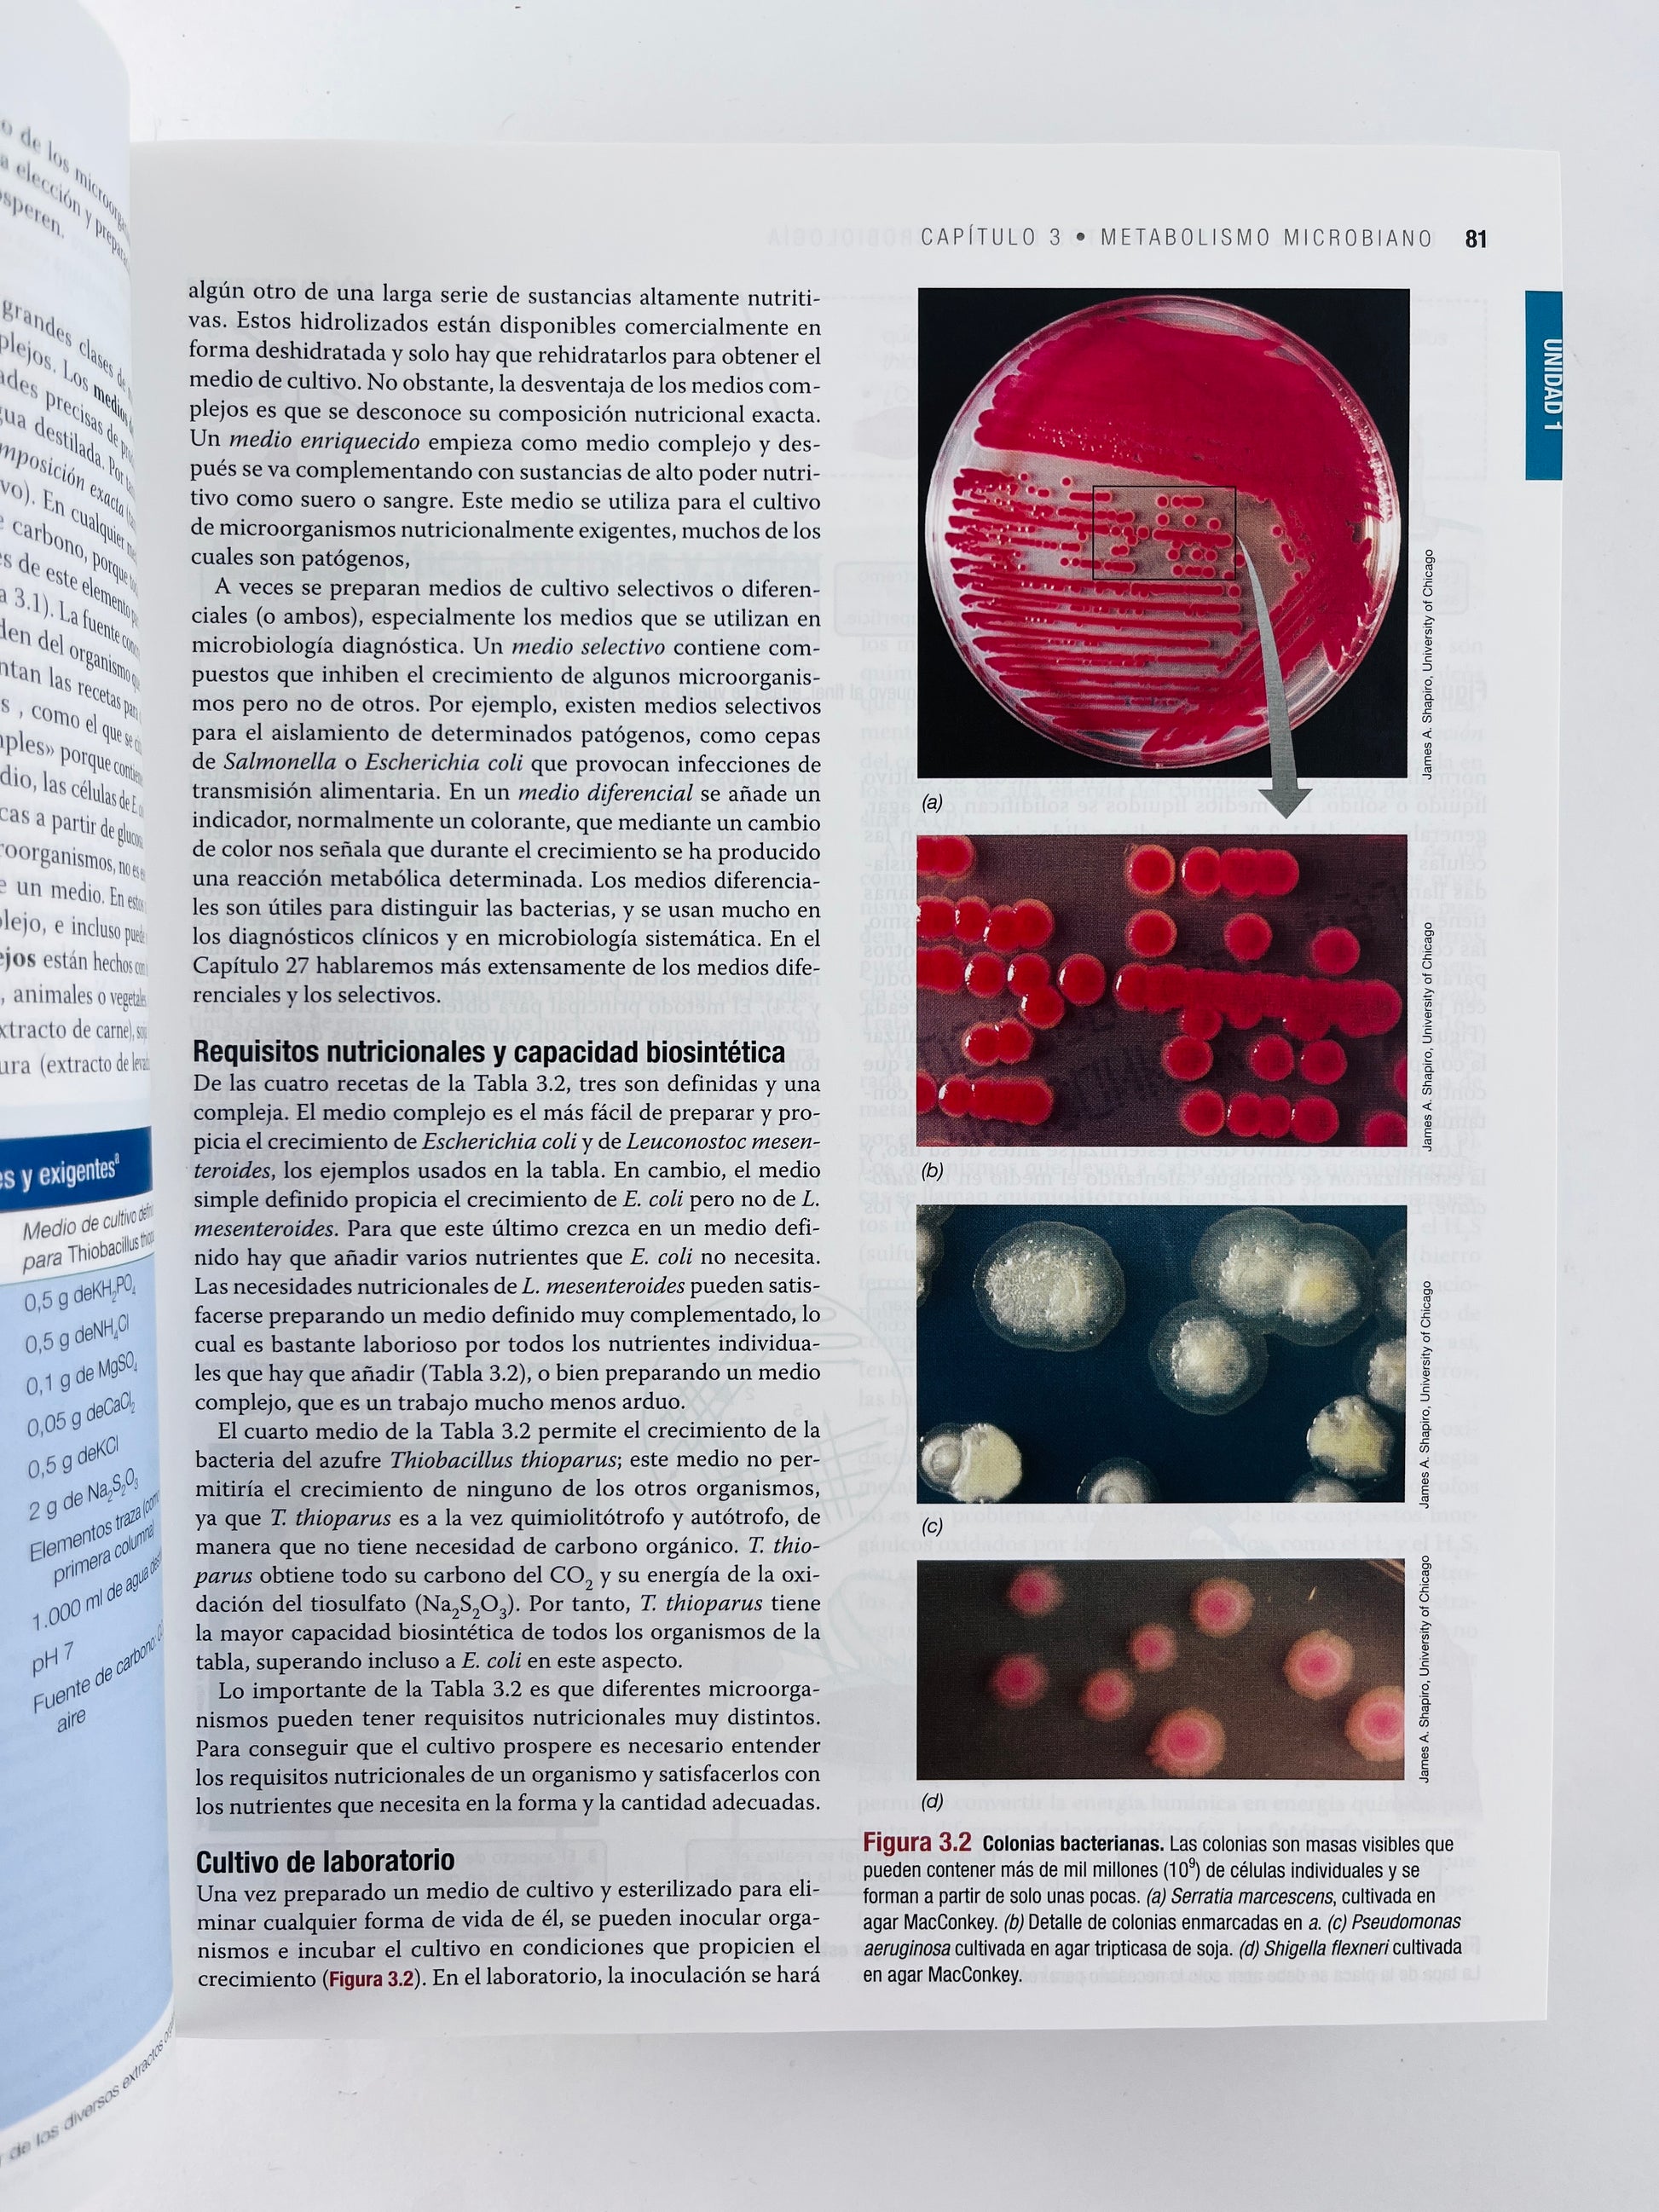
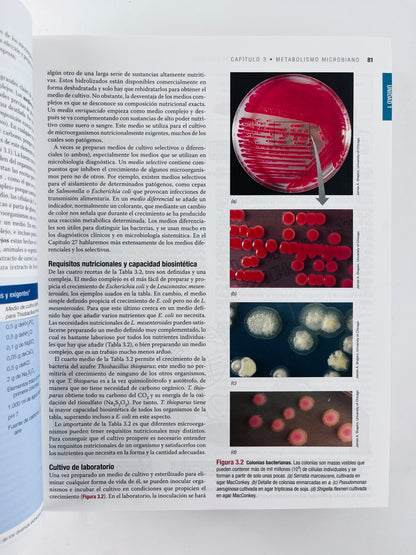

Brock
Biología de los microorganismos 14 edición
Biología de los microorganismos 14 edición
Precio habitual
$285.000
Precio habitual
Precio de oferta
$285.000
Precio unitario
/
por
Estado: Usado 8/10
Los gastos de envío se calculan en la pantalla de pago.
Característica:
Biología
No se pudo cargar la disponibilidad de retiro
Share
Esta nueva edición de Biología de los Microorganismos está reorganizada con imaginación, guía al estudiante a través de los seis principales temas de la microbiología del siglo XXI. Estos seis temas son Evolución, Estructura y función celular, Vías metabólicas, Flujo de información y Genética, Sistemas microbianos, e Impacto de los microorganismos.
Con un trabajo artístico mejorado y revisado con imágenes y con cerca de 200 fotografías nuevas en color, el libro presenta la microbiología como la ciencia visual que es.
Con esta 14a edición los estudiantes se beneficiarán del énfasis que pone el libro en la investigación de vanguardia, de una introducción integradora en la microbiología molecular moderna.
1136 Páginas - Tapa blanda
Código: 9788490352793
Ver todos los detalles